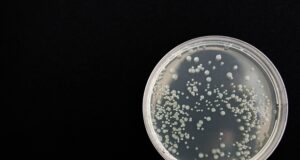

Sistem Peringatan Dini Sebelum Ledakan Supernova Dikembangkan
Para astronom dari Liverpool John Moores University dan University of Montpellier telah merancang sistem 'peringatan dini' untuk membunyikan peringatan ketika sebuah bintang masif akan...
Para Ilmuwan Menyembuhkan Kebutaan Sejak Lahir Tikus Dewasa
Para peneliti telah menemukan cara untuk mengembalikan penglihatan tikus dewasa yang buta sejak lahir. Tikus ini memiliki kelainan pada retinanya yang disebut sebagai amaurosis...
Bukti Manusia Kerdil Berkulit Hitam Sebelum Kemunculan Orang Austronesia
Penduduk asli Taiwan (kelompok Austronesia) memiliki cerita tentang pemburu-pengumpul bertubuh kerdil yang ada di sana sebelum mereka. Namun, baru sekarang ada bukti yang mengkonfirmasi...
Bagaimana Bakteri ‘Mati’ Bisa Hidup Kembali?
Para ilmuwan telah mendeteksi aktivitas tak terduga dalam spora bakteri yang sudak tidak aktif. Untuk pertama kalinya menunjukkan bahwa meskipun ketika mereka secara fisiologis...